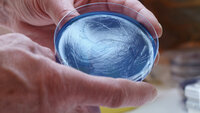
Pseudomonas aeruginosa Bildet viser en petriskål med Pseudomonas aeruginosa.

Innlegg av Nina Hernæs som journalist:
– Vi lurte på om vi hadde sviktet på noe som gjorde at tre pasienter mistet livet
Men deres årvåkenhet forhindret at enda flere ble smittet.
Bakterieutbruddet: – Fraråder bruk av alle Oasis-produkter
Kan ikke utelukke at flere produkter enn vaskekluter er kontaminert med Pseudomonas aeruginosa.
Årets influensavaksine ser ut til å virke uvanlig dårlig
Særlig eldre ser ut til å være dårlig beskyttet av årets vaksine.
Barnesykepleierne: – Det er alles ansvar å ivareta syke barns søsken
Det er ikke bare helsepersonell med barnekompetanse som skal ivareta friske søsken, mener Kirsti Egge Haugstad, leder i Barnesykepleierforbundet.
– Jeg tror ikke en intensivavdeling kan driftes i dress fra et annet sted
Sylvi Vullum har stilt store krav til sykepleierne sine under pandemien. Det hun fikk tilbake, gjorde henne helt paff.
Bakterieutbruddet: Funn av Pseudomonas aeruginosa på Ahus og Kalnes
Flere sykehus leter etter bakterien i en type prefuktede vaskekluter. Nå er den funnet i kluter fra flere batcher.
Bakterieutbruddet: Har funnet Pseudomonas aeruginosa i flere kluter
Det er funnet Pseudomonas aeruginosa i kluter fra en batch til, opplyser smittevernoverlege Egil Lingaas på Oslo universitetssykehus.
Økende forekomst av influensa – ikke for sent å ta vaksine
FHI sier det vanskelig å vite hvor stor økningen vil bli.
– Nå jobber vi for å finne omfanget av utbruddet
Uten årvåkne klinikere kunne utbruddet med Pseudomonas aeruginosa gått under radaren. Nå er FHI spent på om bakterien bare er i Norge.
Dette er sykehusene hvor Pseudomonas aeruginosa er oppdaget
Sykehus i alle helseregioner er rammet av utbruddet med Pseudomonas aeruginosa. Over én million pakker med vaskekluten, som FHI antar er smittekilden, ble distribuert i 2021.